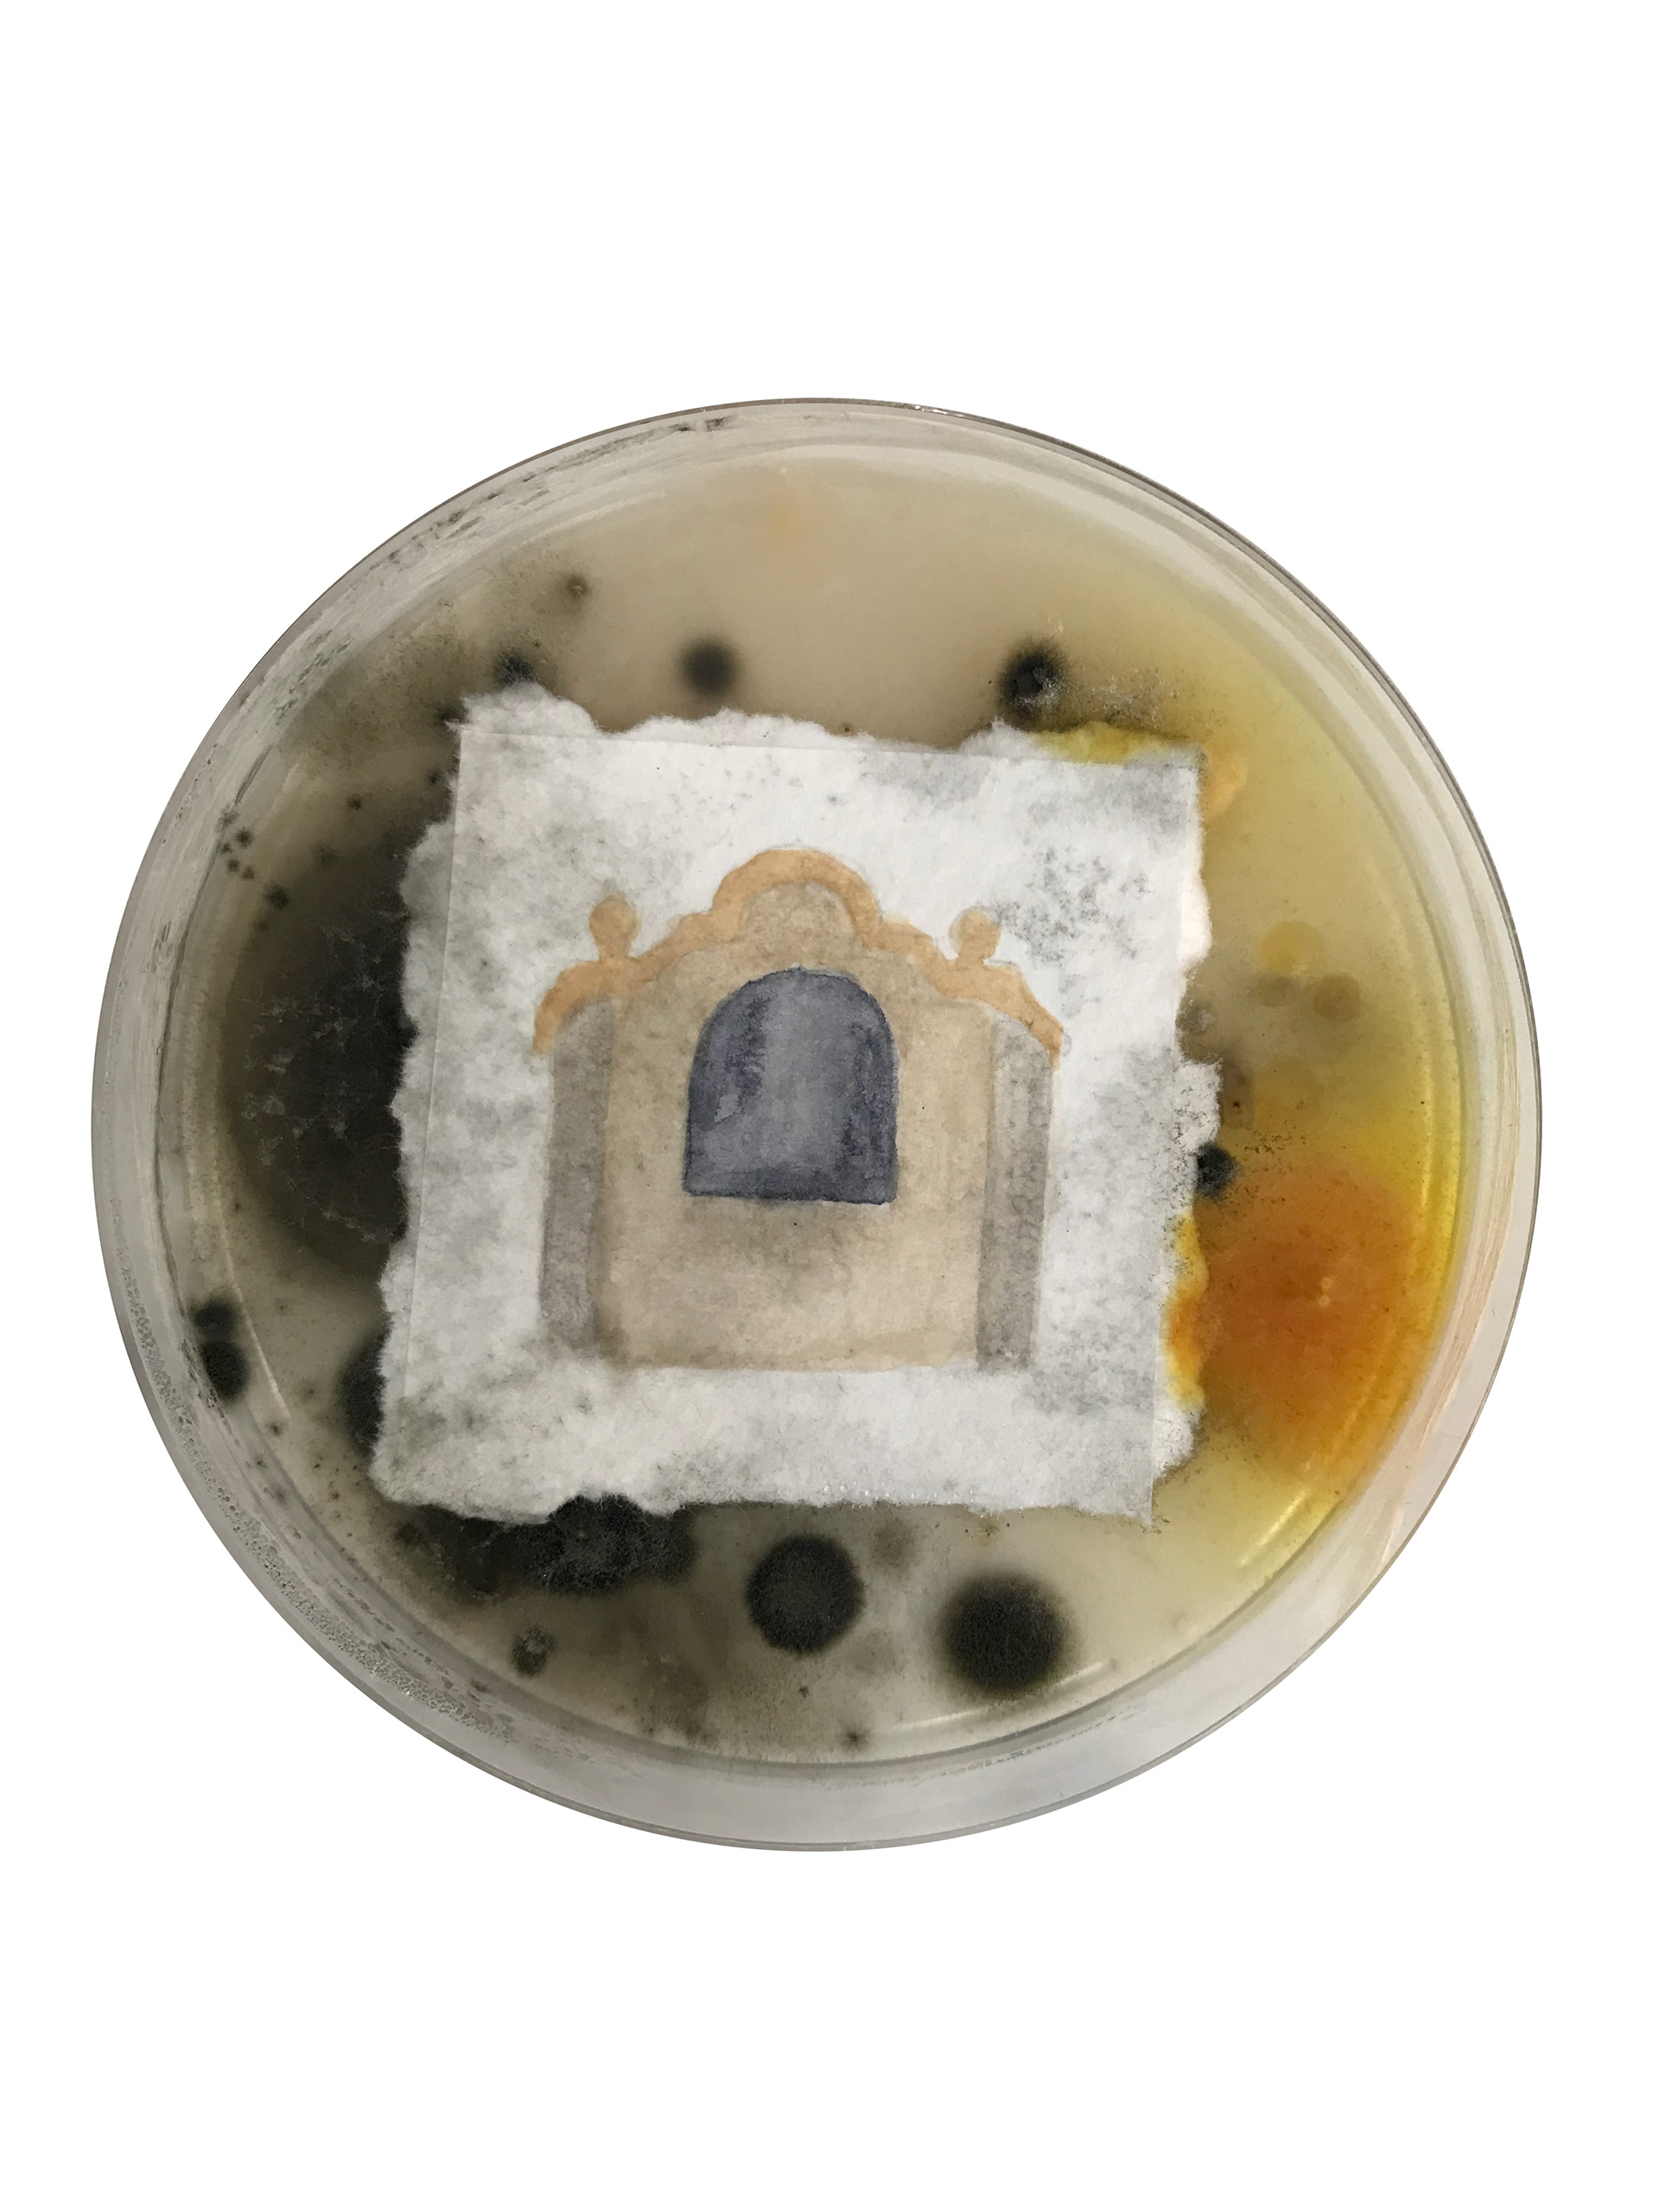
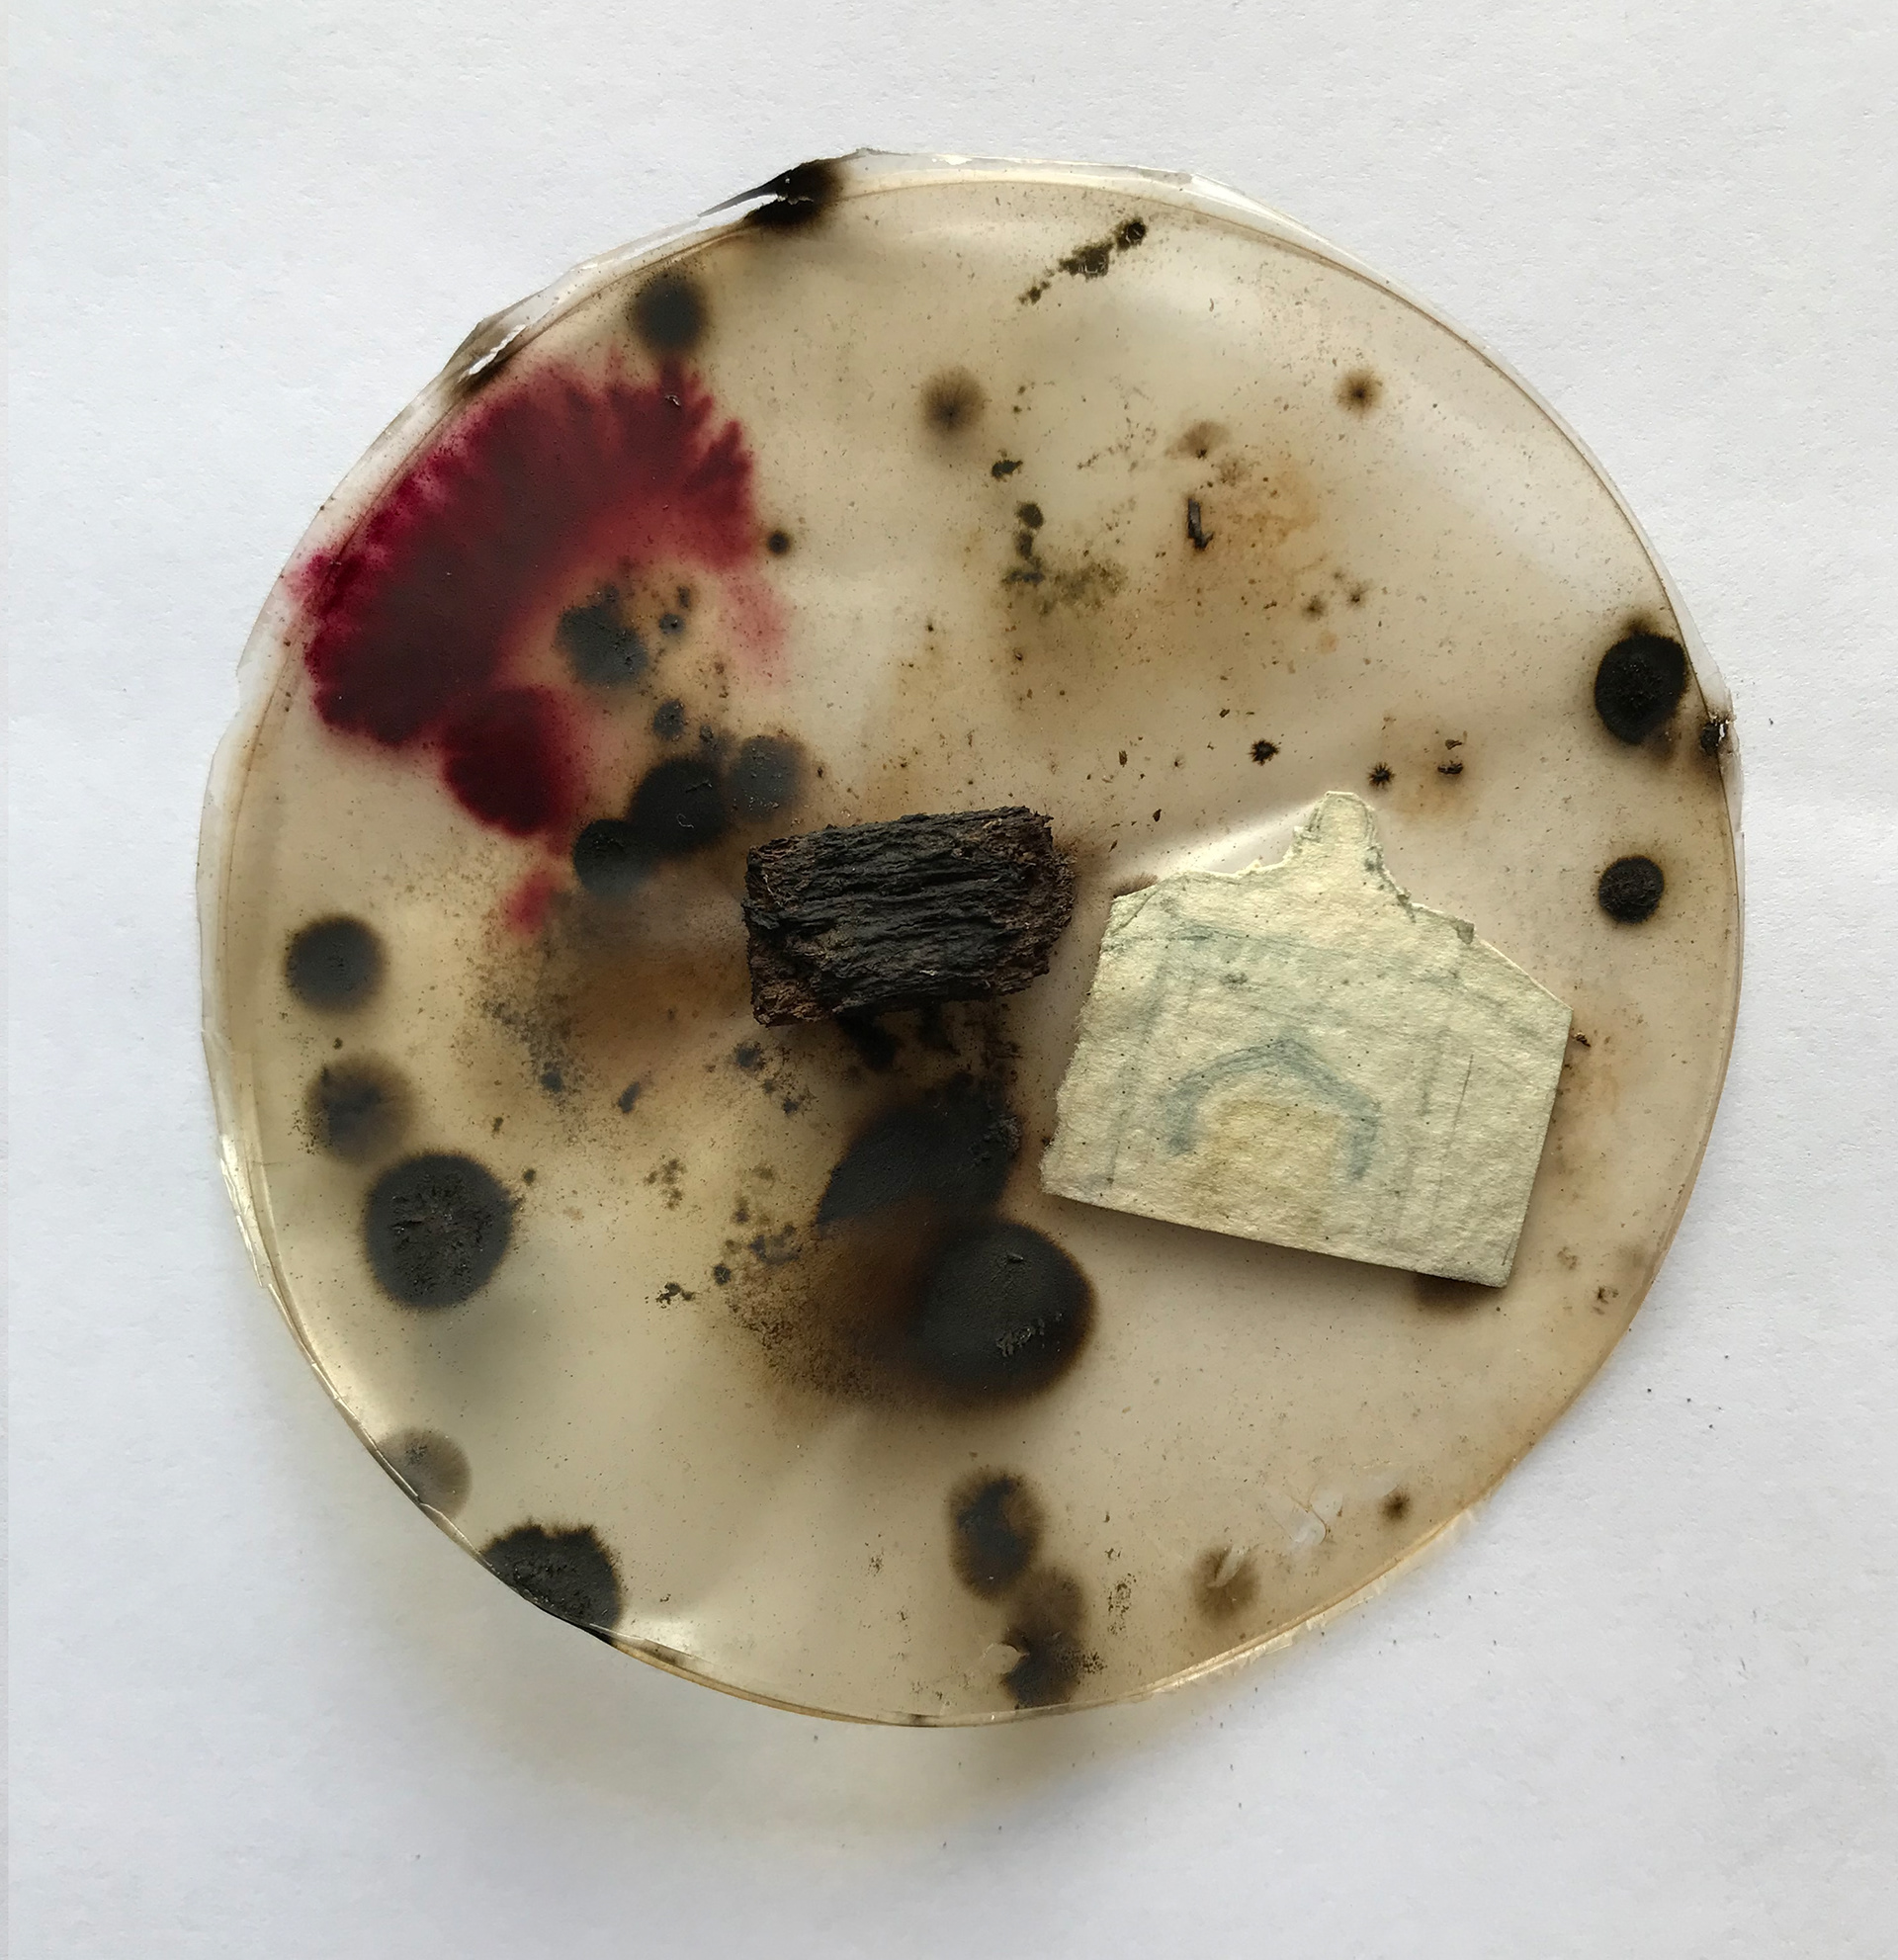

Este trabalho de arte propõe a coleta de fungos e esporos em vários territórios abandonados e cidades-fantasma, cultivando-os em placas de Petri para posteriormente transferi-los para papéis, formando um desenho colaborativo entre a artista e o reino fungi. Espécies diversas – incluindo fungos – coexistem e se entrelaçam em ecossistemas perturbados pela ação humana. Nesta obra, a coleta de esporos em territórios abandonados alude ao conceito de emaranhamento de diferentes tipos de vida em diferentes tempos: ao fazer prosperar fungos coletados em espaços abandonados por populações humanas, traz-se para o visível algo de uma vida que existiu um dia nesses locais, evocando os fantasmas dessas paisagem e rastros de múltiplos passados invisíveis.
Os fungos revelam temporalidades diferentes das nossas. Potencialmente imortais, eles não morrem com o passar do tempo e se espalham continuamente em redes de filamentos renovados. Esses fungos fantasmas mostram-nos temporalidades múltiplas, nas quais vidas invisíveis e contínuas coexistem com paisagens já esquecidas pelos humanos. Ao prestar atenção no tempo dos fungos, em vez de os impor o nosso, abrimo-nos para a possibilidade de um tipo diferente de habitabilidade, onde paisagens são efêmeras em comparação com a resiliência das espécies. Essa obra é, portanto, uma cartografia viva dos intervalos e margens do tempo, onde o presente é apenas uma camada em meio a tantas outras que habitam e persistem no que chamamos de ruínas.
This artwork proposes the collection of fungi and spores from various abandoned territories and ghost towns, cultivating them in Petri dishes to later transfer them onto paper, creating a collaborative drawing between the artist and the fungal kingdom. Diverse species – including fungi – coexist and intertwine within ecosystems disrupted by human action. In this work, the collection of spores from abandoned territories alludes to the concept of entanglement among different types of life across various times: by cultivating fungi gathered from spaces abandoned by human populations, something of a life that once existed in these places is brought into visibility, evoking the ghosts of these landscapes and traces of multiple, invisible pasts.
Fungi reveal temporalities different from our own. Potentially immortal, they do not perish with the mere passage of time, but rather spread continuously in networks of self-renewing filaments. These ghost fungi reveal to us multiple temporalities, where invisible, continuous lives coexist with landscapes already forgotten by humans. By attuning to the fungi’s sense of time rather than imposing our own, we open ourselves to the possibility of a different kind of habitability, where landscapes are ephemeral compared to the resilience of species. This work is, therefore, a living cartography of the intervals and edges of time, where the present is but one layer among many others that inhabit and persist in what we call ruins.
Fungi reveal temporalities different from our own. Potentially immortal, they do not perish with the mere passage of time, but rather spread continuously in networks of self-renewing filaments. These ghost fungi reveal to us multiple temporalities, where invisible, continuous lives coexist with landscapes already forgotten by humans. By attuning to the fungi’s sense of time rather than imposing our own, we open ourselves to the possibility of a different kind of habitability, where landscapes are ephemeral compared to the resilience of species. This work is, therefore, a living cartography of the intervals and edges of time, where the present is but one layer among many others that inhabit and persist in what we call ruins.



Estudos sobre desenvolvimento de micélios e biomateriais, com Adriana Fukunari, 2024.
Serra da Capivara, Piauí, Brasil, 2024.








A partir de uma folha colhida na Serra da Capivara,
coletei um fungo presente na folha
e o deixei crescer sob um pequeno desenho.
coletei um fungo presente na folha
e o deixei crescer sob um pequeno desenho.
From a leaf collected in Serra da Capivara, I collected a fungus present on the leaf and let it grow under a small drawing.
Residência Epecuén
Em novembro de 2024, participei da Residência Epecuén, entre Carhué e a vila de Epecuén, nas Pampas argentinas. A vila, outrora um balneário turístico, sofreu uma inundação massiva em 1985, causada por agência humana, que causou a destruição completa do local e a deixou submersa nas águas do lago Epecuén por 20 anos. O lago tem uma salinidade altíssima, e tudo foi consumido pela água e pelo sal, exceto os líquens – associações entre fungos e algas que resistem a ambientes extremos.
Por duas semanas coletei esses líquens, cujos fungos, em simbiose, sobrevivem à salinidade, e os transferi para aquarelas de edifícios emblemáticos de Carhué, cidade que acolheu os deslocados de Epecuén. Assim como os líquens, essa relação entre os territórios é feita de interdependência: Carhué carrega nas ruínas de sua arquitetura as memórias de uma tragédia que redefiniu identidades. As manchas fúngicas nas aquarelas não são contaminação, mas escritas colaborativas – um diálogo entre espécies que, como propõe Donna Haraway, nos convida a 'habitar o problema' de mundos em colapso. Os fungos, aqui, não são invasores, mas coautores de uma cartografia da resiliência.
Epecuén Residency
In November 2024, I participated in the Epecuén Residency, located between Carhué and the village of Epecuén, in the Argentine Pampas. The village, once a popular tourist resort, suffered a massive flood in 1985, caused by human activity, which led to the complete destruction of the area and submerged it under the waters of Lake Epecuén for 20 years. The lake has extremely high salinity, and everything was consumed by the water and salt, except for the lichens – associations between fungi and algae that survive in extreme environments.
For two weeks, I collected these lichens, whose fungi, in symbiosis, survive the salinity, and transferred them onto watercolors of iconic buildings of Carhué, the city that hosted the displaced people of Epecuén. Just like the lichens, the relationship between the territories is one of interdependence: Carhué carries in the ruins of its architecture the memories of a tragedy that redefined identities. The fungal stains on the watercolors are not contamination, but collaborative writings – a dialogue between species that, as Donna Haraway proposes, invites us to "inhabit the problem" of collapsing worlds. The fungi here are not invaders, but co-authors of a map of resilience.

Esboço do mapa do lago Epecuén, onde foram colhidos os líquens. / Sketch of the map of Lake Epecuén, where the lichens were collected.

O que é e como se forma um líquen? / What is a lichen and how is it formed?

O mapa e pedaços de objetos de onde foram coletados os líquens.
Trabalho exposto na Casa de Cultura de Carhué, Argentina. /
The map and pieces of objects from where the lichens were collected.
Work exhibited at the Casa de Cultura in Carhué, Argentina.

Epecuén e Carhué são territórios que tem entre si uma relação simbiótica. A partir da inundação de Epecuén, muitas pessoas foram acolhidas por amigos e familiares em Carhué: a própria identidade da cidade de Carhué ficou presa à tragédia que se passou em 1985. Até hoje os moradores mais antigos falam sobre os momentos mais dolorosos da inundação com pesar e respeito pelos que mais sofreram com a tragédia. Tentei, nesse trabalho, desenhar prédios emblemáticos da cidade de Carhué que pudessem ser contaminados pelos fungos encontrados em volta do lago. O resultado é um desenho também colaborativo e simbiótico com os fungos que sobreviveram à inundação.
Epecuén and Carhué are territories that share a symbiotic relationship. After the flooding of Epecuén, many people were welcomed by friends and family in Carhué: the very identity of Carhué became intertwined with the tragedy that occurred in 1985. To this day, the older residents speak about the most painful moments of the flood with sorrow and respect for those who suffered the most from the tragedy. In this work, I tried to draw emblematic buildings of Carhué that could be contaminated by the fungi found around the lake. The result is also a collaborative and symbiotic drawing with the fungi that survived the flood.